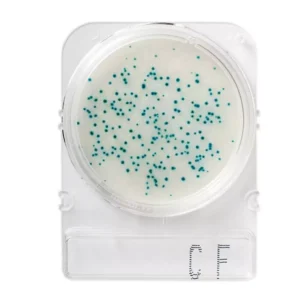
Teste Rápido Microbiológico Compact Dry Coliforme Cf

Prlabor – Retire seu pedido 2 dias úteis após a sua compra. Rua Pio XII, 573, Neva, Cascavel/PR – Atendimento de Segunda à Sexta das 08:00 às 12:00 e 13h30 às 17:45.
Em casos específicos (produtos com temperatura controlada, equipamentos, etc) realizamos comparações de prazo de entrega por correio e transportadoras e tomamos a liberdade de despachar pelo Frete mais rápido e/ou seguro.
Compact Dry são placas prontas para detecção e quantificação microbiológicas em matérias-primas, alimentos e ambiente. É um método de ensaio microbiológico pronto para uso que permite uma perfeita absorção das amostras inoculadas. Permite quantificar a maioria das bactérias de interesse para a indústria alimentícia.
Características:
Quantidade na embalagem: 20 ou 100 unidades.
Marca: Nissui.
Imagem meramente ilustrativa.